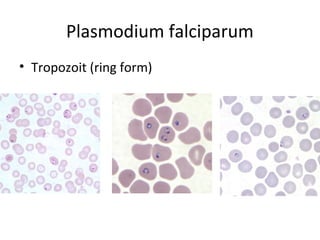
Plasmodium falciparum
• Tropozoit (ring form)
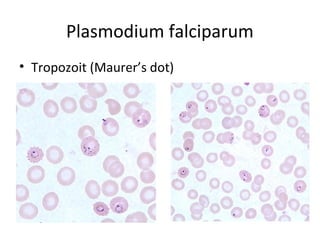
Plasmodium falciparum
• Tropozoit (Maurer’s dot)
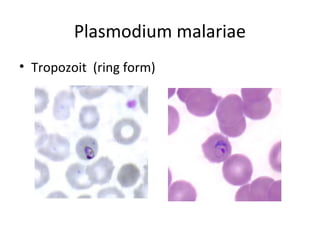
Plasmodium malariae
• Tropozoit (ring form)
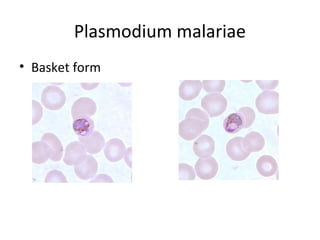
Plasmodium malariae
• Basket form
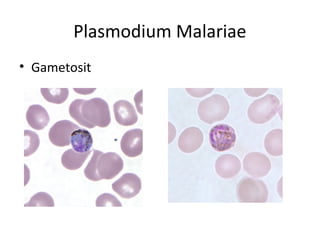
Plasmodium Malariae
• Gametosit
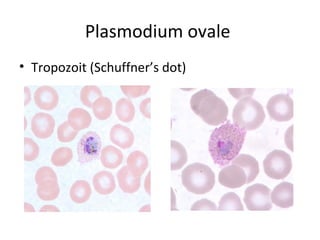
Plasmodium ovale
• Tropozoit (Schuffner’s dot)

More Related Content
PPT
PDF
PPT
PPTX
PPTX
PPTX
Entamoeba hystolitica & entamoeba coli PPT
PPTX
What's hot
PPT
Kumpulan Latihan Soal Ukom D4 (2023) II.ppt DOCX
PPTX
PPT MK PATOFISIOLOGI TBC.pptx PPTX
PPT parasitologi - strongiloides stercoralis & trichinella spiralis PDF
PPTX
Penanganan, penyimpanan, dan pemusnahan sampel PDF
Buku pedoman teknis pemeriksaan parasit malaria PPTX
Pemeriksaan anti sterptolisyn (asto) xi tlm PPTX
PPT
PDF
CARIK CELUP URINE (REFLACTAN) PPT
Diagnosis dan manajemen toksoplasmosis pada ibu hamil PPTX
PPTX
PPTX
Definisi etiologi non dermato dan dermato PPTX
Parasitologi Loa-Loa, Ochocerca volvulus dan Dracunculus medinensis PPTX
PPT
PPTX
DOCX
Praktikum protozoa-picture
- 1.
- 2.
- 3.
- 4.
- 5.
- 6.
- 7.
- 8.
- 9.
- 10.
- 11.
- 12.
- 13.
- 14.
- 15.
- 16.
- 17.
- 18.
- 19.
- 20.
- 21.
- 22.
- 23.
- 24.
- 25.
- 26.
- 27.
- 28.